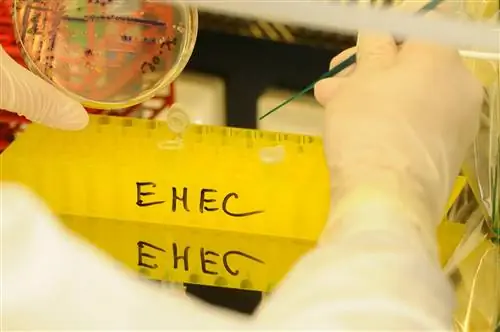
Вспышка ЭГКП в детских садах: как это произошло?

За последние несколько дней в нескольких франконских детских садах стало известно о тяжелой вспышке EHEC. Причина и обстоятельства до сих пор остаются невыясненными.
Согласиться и продолжить чтение Чтобы рассказать эту историю, наши редакторы выбрали видео, которое дополняет статью на данный момент.
Мы используем JW Player от Longtail Ad Solutions, Inc. для воспроизведения видео.. Дополнительную информацию о JW Player можно найти в нашей политике конфиденциальности.
Прежде чем мы покажем видео, нам нужно ваше согласие. Вы можете отозвать свое согласие в любое время, например, в нашем менеджере по защите данных.
Дополнительная информация в нашей политике конфиденциальности. Да, я согласен и хочу увидеть содержание
В районе Франконии несколько детей в разных детских садах недавно заразились кишечными бактериями, некоторые даже серьезно заболели. Теперь есть новости о массовой вспышке EHEC.
Вспышка насильственной ЭГКП в детских садах - тяжело больны 5 детей
Как впервые сообщалось в июле, массовая вспышка заболевания затронула два детских сада в Нюрнберге и Фюрте, которые пострадали. Странно только то, что два разных учреждения сообщили о болезнях.
Через несколько дней выяснилось, что трое детей в Фюрте и двое в Нюрнберге тяжело больны ЭГКП. У малышей в возрасте от двух до шести лет должны быть признаки гемолитико-уремического синдрома (ГУС), который вызывает нарушения свертываемости крови, разрушение эритроцитов или может наступить острая почечная недостаточность. Четверо тяжелобольных в начале августа находились в больнице. Еще пятеро детей также были заражены, но у них были только легкие симптомы, дальнейшие тесты все еще ожидаются.
Кишечно-геморрагические бактерии Escherichia Coli, сокращенно EHEC, обнаруживаются в кишечнике жвачных животных, таких как крупный рогатый скот, овцы, козы, косули или олени. Они могут производить токсины, которые не возражают против животных. Однако бактерии представляют большую опасность для человека: Кровавый понос со судорогами и лихорадкой и серьезные заболевания, такие как ГУС, могут иметь место и со смертельным исходом. Маленькие дети особенно подвержены риску, но у пожилых людей или людей с ослабленной иммунной системой также может развиться тяжелое течение и осложнения.
После вспышки ЭГКП в детских садах: дети идут на поправку
С 1 августа новых случаев не зарегистрировано. В настоящее время ситуация улучшилась, все дети с тяжелой формой ЭГКП выписаны из стационара. Одного пришлось лечить амбулаторно.
Источник EHEC в детских садах до сих пор неизвестен
Даже если было сделано предположение, что кейтеринговая компания может быть ответственна за вспышку, четкая и точная причина может быть еще не определена. Подозрение, что кейтеринговая компания могла занести бактерии в детские сады через продукты питания, в ходе расследования не подтвердилось.
По данным ответственных органов, вспышка EHEC локализована. В настоящее время детские сады закрыты на лето, после чего следует более тщательно соблюдать общие основные меры гигиены.